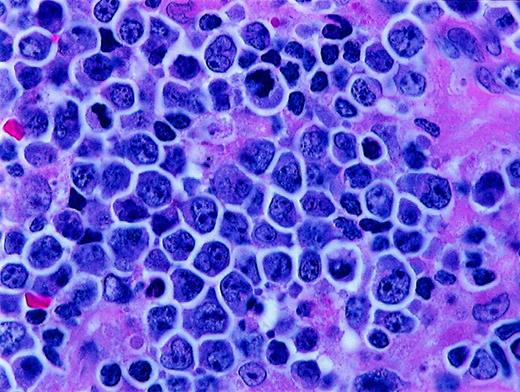
Fig. 2. Histologic features of BLL. / Higher magnification of BLL sample reveals nuclear polymorphism with various nuclear shapes and polylobation of some nuclei (hematoxylin and eosin stain, × 1000).

The Revised European-American Lymphoma classification gives Burkitt-like lymphoma (BLL) provisional status, leaving unresolved the differential diagnosis with Burkitt lymphoma (BL) and diffuse large B-cell lymphoma (DLBCL). This study compared the biologic features of adult BLL and DLBCL. The phenotypic distinction between BLL and DLBCL was determined by immunohistochemical staining of frozen tissue from 13 patients with BLL and 55 patients with DLBCL by using an extensive antibody panel including Ki-67, CD10, CD11a/lymphocyte function–associated antigen 1α (LFA-1α), CD18/LFA-1β, CD58/LFA-3, and CD54/intercellular adhesion molecule, CD8 for tumor-infiltrating cytotoxic T cells (T-TILs), CD44 homing receptor, and p53 and Bcl-2 oncogenic proteins. Compared with DLBCL, BLL had a higher proliferative rate (mean Ki-67, 88% versus 53%), greater expression of CD10 and p53 antigens, and decreased expression of Bcl-2. BLL cases had a consistent absence of one or more cell adhesion molecules (92% versus 27%), low T-TIL numbers, and absence of CD44 homing receptor (92% versus 14%). The t(8;14) translocation was identified in 80% of BLL cases, but no patients with BLL had the t(14;18) translocation. In a 10-year analysis, median survival of patients with BLL was 1.2 years, and that of patients with DLBCL was 2.5 years. Although the proportion of patients cured was similar in the 2 groups, BLL patients had an increased risk of early death. We conclude that BLL can be recognized by its combined morphologic and phenotypic features and that it represents a high-grade lymphoma much closer to BL than DLBCL. Retention of the BLL category or inclusion of BLL as a variant of BL is biologically and clinically more appropriate than absorbing the category of BLL into DLBCL.
Introduction
The category of high-grade Burkitt-like lymphoma (BLL) was proposed as a provisional entity by the International Lymphoma Study Group (ILSG) in the Revised European-American Lymphoma (REAL) classification published in 1994.1 Most BLLs were previously classified as diffuse, undifferentiated, non-Burkitt lymphomas in the Rappaport classification and diffuse, small noncleaved-cell, non-Burkitt lymphomas in the working formulation (WF).2 In the REAL classification, the BLLs were described as diffuse B-cell lymphomas with a high proliferative rate and cytologic characteristics considered borderline between those of classic Burkitt lymphoma (BL) and those of diffuse large B-cell lymphoma (DLBCL). For some cases, it was considered to be impossible to make a histologic distinction between DLBCL with centroblastic or immunoblastic features and BL. The ILSG suggested that the BLLs were probably not related to true BL, despite the considerable morphologic overlap between them.3-6 Overlapping morphologic features of BL and BLL include a very high mitotic rate, prominent cytoplasmic basophilia, cytoplasmic vacuolation on Wright-Giemsa–stained smears, and usually a starry-sky pattern. BL and BLL both typically have “squared-off” cytoplasm that yields a jigsaw puzzle–like pattern. The cells in BL are medium sized and monomorphous, with round nuclei and 2 to 5 basophilic nucleoli. The cells in BLL are slightly larger and show more nuclear variability than BL cells, with an increased prominence of nucleoli (Figure 1 and Figure 2).
Histologic features of BLL.
The lymphoma is diffuse, with a starry-sky pattern due to admixed phagocytic macrophages, and is composed of medium-sized lymphoid cells showing a jigsaw puzzle effect of cytoplasmic borders. The nuclei vary in size and shape, and the mitotic rate is high (paraffin sections stained with hematoxylin and eosin; upper panels, original magnification × 40 and × 100; lower panels, × 400).
Histologic features of BLL.
The lymphoma is diffuse, with a starry-sky pattern due to admixed phagocytic macrophages, and is composed of medium-sized lymphoid cells showing a jigsaw puzzle effect of cytoplasmic borders. The nuclei vary in size and shape, and the mitotic rate is high (paraffin sections stained with hematoxylin and eosin; upper panels, original magnification × 40 and × 100; lower panels, × 400).
Histologic features of BLL.
Higher magnification of BLL sample reveals nuclear polymorphism with various nuclear shapes and polylobation of some nuclei (hematoxylin and eosin stain, × 1000).
Histologic features of BLL.
Higher magnification of BLL sample reveals nuclear polymorphism with various nuclear shapes and polylobation of some nuclei (hematoxylin and eosin stain, × 1000).
In 1994, when the REAL classification was published, the BLL category was not thought to be a histologically reproducible category or a distinct clinicopathologic entity, but the relations among BLL, BL, and DLBCL were not sufficiently clear to allow inclusion of BLL in either the BL or the DLBCL category.1 The lack of reproducibility of the histologic diagnosis of BLL was subsequently confirmed by a study done by the Non-Hodgkin's Lymphoma Classification Project (NHLCP),7 in which the distinction between BLL and DLBCL was one of the most difficult to make in non-Hodgkin lymphoma classification, with only 53% agreement among a panel of expert hematopathologists.
The objective of this study was to determine whether the category of BLL should be retained as a separate category in new lymphoma classifications. To do this, we first defined the phenotypic and genotypic characteristics of a group of cases of adult BLL with the agreed-on REAL classification histologic features. We then compared the biologic features of these BLL cases with those of a group of similarly characterized cases of DLBCL. Frozen tissue from diagnostic biopsies done in 13 patients with BLL in the Southwest Oncology Group (SWOG) Lymphoma Frozen Tissue Repository was studied by using an extensive panel of monoclonal antibodies. When sufficient tissue was available, evaluations were also done with a newly developed fluorescence in situ hybridization (FISH) method to detect the t(8;14)(q24;q32) (c-Myc/JH) translocation. Finally, tissue was also tested for the presence of the t(14;18)(q32;q21) translocation by using polymerase chain reaction (PCR) analysis. The phenotypic, genetic, and clinical features of these BLL cases were delineated and compared with those in a series of 55 concurrently accrued cases of DLBCL (category G of the WF) for which frozen tissue was available in the same repository.
Patients, materials, and methods
Patient selection and histologic diagnosis
Laboratory assays in this study were performed predominantly on frozen tissue from 68 SWOG patients with lymphoma who represented all of B-cell WF category G (diffuse large-cell lymphoma) and WF category J (diffuse, small noncleaved-cell, non-Burkitt) lymphoma cases in which snap-frozen tissue was available in the SWOG repository. Histologic review confirmed that 13 of these patients had BLL and 55 had DLBCL. Paraffin-block samples were available for 10 of the patients with BLL and 25 of those with DLBCL.
The histologic diagnoses for all 68 patients were confirmed by a SWOG review panel of hematopathologists (authors R.M.B., T.M.G., C.K., C.L., C.S., and R.T.). The panelists classified the cases according to agreed-on REAL classification criteria; all cases were reviewed and histologic diagnoses were generated independently after a discussion of the criteria and a consensus review of representative cases. Most of the 68 patients in this study were from SWOG 8516, a group of 899 patients with intermediate- and high-grade lymphomas treated with doxorubicin-based second- and third-generation chemotherapy regimens.8 Of these 899 patients, 573 were originally classified as having diffuse large-cell lymphoma (WF categories G and H) and 75 had an original review diagnosis of diffuse, small noncleaved-cell, non-Burkitt lymphoma (WF category J). The final groups of BLL and DLBCL cases in this study were identified after additional histologic review by the panel and included only cases for which all reviewers independently confirmed the diagnosis and frozen tissue was available for study. Cases about which there was any disagreement regarding diagnosis were excluded. Also excluded were cases in which histologic progression to BLL from a low-grade B-cell lymphoma occurred.
Patient characteristics
Table 1 shows important clinical and prognostic factors in the 2 cohorts in the study. The BLL group was slightly younger, had a higher proportion of men, and had a better performance status than the DLBCL group; however, the number of patients in the BLL group was too low to allow determination of significant differences between the 2 groups. Median age of the patients with BLL was 47 years (range, 28-69 years), whereas that of the patients with DLBCL was 58 years (range, 29-87 years). Patients older than 60 years comprised 10% of the BLL group and 33% of the DLBCL patients. The BLL group included a higher proportion of men (10 men and 3 women); the DLBCL group included 34 men and 21 women. Ten of the patients with BLL were negative for human immunodeficiency virus (HIV); 3 were positive. All the patients with DLBCL were HIV negative. None of the BLL patients had a poor performance status at diagnosis, whereas 18% of the DLBCL patients did.
Immunohistochemical staining
Immunohistochemical (IHC) staining was done on snap-frozen biopsy tissue specimens from the 68 SWOG lymphoma patients with tissue banked in the SWOG repository. Frozen tissue was used to eliminate the artifacts from fixation and tissue processing that complicate IHC analysis of paraffin-embedded tissue and to allow demonstration of some antigens (cell adhesion molecules [CAMs]) that cannot be reliably assessed in paraffin sections. Limited paraffin-section IHC analysis was also done in 35 cases (10 BLL and 25 DLBCL) for which paraffin-block samples were available. IHC staining results for the 13 patients who were classified on review as having BLL and the 55 patients with a review diagnosis of DLBCL were then specifically compared. Lymphomas identified by immunophenotyping as peripheral T-cell lymphomas were excluded from the study.
The immunostaining assays used a standard biotin-streptavidin–linked peroxidase detection method as described previously.9 Briefly, the first stage included either a monoclonal mouse antihuman antibody or a polyclonal rabbit antihuman antibody. The secondary antibodies were either a biotinylated goat anti–mouse or goat anti–rabbit immunoglobulin G (IgG). The biotin was linked to streptavidin with bound peroxidase. The streptavidin-peroxidase complex was then allowed to react with diaminobenzidine and enhanced with copper sulfate. The immunostaining results were reviewed, and a consensus interpretation was then used for further analysis. A reaction was considered positive if at least 30% of the lesional cells showed a signal, a traditional cut-point for SWOG lymphoma biologic studies. The percentages of positive cells for all antibody staining results except those for Ki-67 and CD8 were estimated. The percentages of Ki-67–positive cells and CD8+ cells in these frozen sections were determined by an actual count, and the percentage of positive cells was expressed as the percentage of all cells in the areas counted, including background small lymphocytes, histiocytes, and other cells.
The primary antibodies to cell-surface, cytoplasmic, and nuclear antigens included a battery of lineage, maturation, proliferation, oncogene, and CAM antibodies. T-cell antibodies included CD1a, CD2, CD3, CD4, CD5, CD7, CD8, CD25, and CD56 (Becton Dickinson, Mountain View, CA), polyclonal CD3 (Dako, Carpinteria, CA), and CD8 (gift of David Mason, Oxford, United Kingdom). Also studied were the CD10/CALLA antibody; the CD19, CD20, CD21, and CD22 B-cell antibodies; and the human IgM, IgG, IgD, and IgA heavy-chain and κ and λ light-chain antibodies (Becton Dickinson). The oncogene antibodies were to cytoplasmic Bcl-2 oncoprotein (Dako) and the nuclear p53 antigen (Dako and Oncogene Sciences, Cambridge, MA). The proliferation marker was MIB-1/Ki-67 (Dako). Antibodies to CAMs and homing receptors included CD11a/lymphocyte function–associated antigen 1α (LFA-1α), CD18/LFA-1β, CD58/LFA-3, and CD54/intercellular adhesion molecule (ICAM) (Immunotech, Marseilles, France), and CD44 (Vector Labs, Burlingame, CA).
Epstein-Barr virus in situ hybridization
To preserve the scarce frozen tissue for our cases, in situ hybridization for Epstein-Barr virus (EBV) was done on the available paraffin blocks from 10 of the BLL patients and 25 of the DLBCL patients by one of us (M.L.G.), as previously described,10by using digoxigenin-labeled (Boehringer Mannheim, Indianapolis, IN) riboprobes. Probe templates for Epstein-Barr–encoded RNA 1 (EBER1) (RA386) and U6 (RA390) were donated by Dr Richard Ambinder (Johns Hopkins University, Baltimore, MD).11 Antisense EBER1 probe is complementary to the EBER1 transcript characteristic of latent EBV infection. Antisense U6 probe recognizes a ubiquitous cellular transcript that was used to confirm preservation of RNA integrity. Cases were interpreted as positive for EBV if the lymphoma cells showed nuclear expression of EBER1 in areas having adequate RNA preservation. Positive controls included tissue biopsy specimens from patients with infectious mononucleosis and Reed-Sternberg cells in biopsy specimens from patients with Hodgkin disease. Stromal cells in the same tissues served as endogenous negative controls.
FISH analysis for t(8;14)(q24;q32)
FISH analyses were also done on the paraffin-embedded blocks of tissue from the 10 BLL patients and 3 of the DLBCL patients. Whole nuclei were isolated from 3 50-μm sections per sample. The sections were deparaffinized and rehydrated as described previously,12 digested with proteinase K, and resuspended.13 A 10-μL suspension was placed on sialin-treated slides and allowed to air-dry overnight. The slides were fixed in 1% formaldehyde solution, air-dried, denatured in 70% formamide and 2 × standard saline citrate at 72°C for 12 minutes, and then dehydrated.
A combination of 3 probes was used to detect the t(8;14)(q24;q32) translocation. Two YAC clones, I2 and P72 (provided by Dr Maria Luisa Veronese, Jefferson Medical College), that span the c-Myc locus on 8q24 were combined to detect the different 8q24 breakpoints.14YAC clone DNA was isolated and amplified by using Alu-PCR.15 YAC clone DNA was labeled by nick translation with Spectrum Green deoxyuridine triphosphate (Vysis, Downers Grove, IL) according to the manufacturer's instructions. The I2/P72 combined probe (5 μL) was denatured for 5 minutes at 72°C before mixing with 5 μL Tel 14q(14q32.3-qter) digoxigenin-labeled probe, which spans the immunoglobulin heavy-chain gene (IgH) locus (Oncor, Gaithersburg, MD). The probe mixture was applied, a coverslip (22 × 22 mm) was applied to the slide, and hybridization was done at 37°C overnight. Posthybridization washes and signal detection were carried out as described previously.14
The FISH slides were scored by using a Nikon microscope equipped with fluorescein isothiocyanate (FITC)/Texas Red and FITC filters. Scoring criteria were as follows: (1) 200 nuclei per case were scored; (2) only intact, nonoverlapping nuclei were scored; (3) nuclei had to contain 4 distinct signals; and (4) fusion was determined by touching or overlapping red and green signals. Cut-off values described below for the FISH analysis were determined by using 9 lymphoma samples positive for the t(8;14) translocation and 11 lymphoma samples negative for it. To distinguish true fusion signals from normal background, the cut-off value was set at 3 SD above the mean percentages from the t(8;14)-negative lymphoma samples as defined previously.16The mean ± SD percentage of nuclei with a false-positive fusion signal was 3.4% ± 0.87% (P = .95; n = 11), thus setting the value of more than 6% as positive for the t(8;14) translocation. Positive controls included 2 paraffin-embedded cell pellets from the Raji and Ramos t(8;14)-positive cell lines and paraffin-embedded sections from a BL proven to be positive for t(8;14) by standard cytogenetic analysis. Paraffin sections from an anaplastic large-cell lymphoma served as negative controls.
PCR analysis for t(14;18)(q32;q21)
PCR analysis was done on DNA extracted from paraffin-embedded lymphoma tissue from 10 of the patients with BLL and 25 of the patients with DLBCL and on frozen tissue from 18 additional DLBCL patients. Testing for the major breakpoint region (MBR) of the t(14;18) translocation was done as described previously.17 Briefly, DNA was extracted from 10-μm paraffin sections by using a phenol-chloroform extraction technique. Hot-start PCR for a total of 35 cycles was used. The MBR primer sequence was as follows: 5′-GAGAGTTGCTTTACGTGGCCTG-3′. The MBR primers were coupled with a consensus JH primer (5′-ACCTGAGGAGACGGTGACC-3′). The PCR product was blotted and hybridized with a phosphorus 32–labeled probe specific for the MBR (5′-CAACACAGACCCAGAGC-3′) internal to the amplified sequences. Appropriate positive and negative controls were included in each PCR run. The human β-globin gene18 was amplified for each case to confirm the presence of amplifiable DNA.
Statistical analysis
The survival-curve analysis did not include data from all the patients in the biologic studies; rather, survival-curve comparisons were restricted to a subgroup of 43 patients (33 with DLBCL and 10 with BLL). These patients all had bulky stage II, III, or IV disease and had initially received therapy with a second- or third-generation, doxorubicin-containing regimen. Patients with stage I or nonbulky stage II disease and patients who did not initially receive doxorubicin-containing therapy were excluded from the survival analyses. Survival time was measured from the date of registration to death or date of last contact. The BLL survival curve included 3 HIV-positive patients and 7 HIV-negative patients; inclusion of the HIV-positive patients did not alter the survival-curve or median-survival findings compared with inclusion of the HIV-negative patients alone. Overall survival rates were estimated according to the method of Kaplan and Meier.19 Survival analyses were done on patient data received at the SWOG Statistical Center by February 15, 1999.
Results
Histologic review
Of the 75 lymphomas originally classified in the WF as diffuse, small noncleaved-cell, non-Burkitt lymphoma (category J), 39 were reclassified as BL (3 cases) or BLL (36 cases) by all reviewers. Of these classic cases, 13 BLL cases and no BL cases had frozen tissue available in the SWOG repository for extensive additional immunophenotyping and molecular genetic studies. Frozen-tissue blocks for 55 confirmed cases of DLBCL were also available in the repository.
In 36 of 75 cases, the original histologic diagnosis of diffuse, small noncleaved-cell, non-Burkitt lymphoma was not confirmed by all reviewers. These cases fell into several distinct categories. For 17 of the 36 cases, more than one reviewer thought they would be more appropriately classified as DLBCL, and 3 of the 17 were classified as DLBCL cases by all SWOG reviewers. Eight patients had histologic evidence of a pre-existing low-grade B-cell lymphoma, with focal transformation to BLL; 4 of these had a component of follicular lymphoma, 3 had a probable marginal-zone lymphoma component, and 1 had a low-grade B-cell component that could not be further subclassified. Eight additional cases were classified on review as mantle cell lymphoma, usually the blastic variant, and 3 cases were considered unclassifiable. All cases in which the diagnosis was not confirmed by all reviewers were excluded from the study.
Immunophenotyping
Extensive immunologic analyses were performed on frozen sections from the 13 patients with confirmed BLL and the 55 patients with confirmed DLBCL. Of these patients with frozen tissue available, paraffin blocks were also available for limited additional immunophenotyping for 10 patients with BLL and 25 with DLBCL. The immunophenotyping results from the lymphoma cohorts were compared (Table 2 and Figure 3). Some of the typical immunophenotypic features of the BLL cases in this study are shown in Figure 4 and Figure5. All BLL and DLBCL cases were positive for at least one pan–B-cell marker. Expression of B-cell–associated antigens was similar in the 2 groups, but CD10 expression was much more common in the BLL group (85% versus 27%).
Contrast of phenotype and genotype between BLL and DLBCL.
Values are percentages of positive cases unless otherwise indicated.
Contrast of phenotype and genotype between BLL and DLBCL.
Values are percentages of positive cases unless otherwise indicated.
Histologic and phenotypic features of BLL.
(A) Starry-sky pattern (hematoxylin and eosin stain of paraffin section, × 400). (B) Nearly all neoplastic cells are proliferating, as demonstrated by reactivity with Ki-67 (frozen section, × 400). (C) Strong CD20 reactivity of BLL cells (frozen section, × 400). (D) Positivity for EBV detected by EBER in situ hybridization (paraffin section, × 400).
Histologic and phenotypic features of BLL.
(A) Starry-sky pattern (hematoxylin and eosin stain of paraffin section, × 400). (B) Nearly all neoplastic cells are proliferating, as demonstrated by reactivity with Ki-67 (frozen section, × 400). (C) Strong CD20 reactivity of BLL cells (frozen section, × 400). (D) Positivity for EBV detected by EBER in situ hybridization (paraffin section, × 400).
Additional phenotypic features of BLL.
Upper left shows strong expression of CD10 in BLL sample (frozen section, × 400); upper right, near-absent expression of Bcl-2 in BLL cells (paraffin section, × 400); lower left, near-absent expression of LFA in BLL cells (frozen section, × 400); and lower right, low T-TIL numbers as assessed by reactivity of only rare cells with CD8 (frozen section, × 400).
Additional phenotypic features of BLL.
Upper left shows strong expression of CD10 in BLL sample (frozen section, × 400); upper right, near-absent expression of Bcl-2 in BLL cells (paraffin section, × 400); lower left, near-absent expression of LFA in BLL cells (frozen section, × 400); and lower right, low T-TIL numbers as assessed by reactivity of only rare cells with CD8 (frozen section, × 400).
The mean percentage of Ki-67–positive cells in the BLL cases was 88%, which was significantly higher than the mean of 54% Ki-67–positive cells in the DLBCL cases. The range of Ki-67–positive cells was much narrower for the BLL cases (78%-95%) than for the DLBCL cases (10%-95%). Of the BLL cases, 12 of 13 (92%) had a Ki-67 rate higher than 80%, whereas only 9 of 55 DLBCL cases (16%) had a proliferative rate higher than 80%.
For most of the BLL cases (80%), there were few (< 6%) CD8+ tumor-infiltrating cytotoxic T cells (T-TILs), a finding observed in only 24% of DLBCL cases. The mean T-TIL percentage for the BLL cases was 3.2%; that for the DLBCL cases was 15.7%. As with the Ki-67 values, the range of T-TIL percentages was much narrower for the BLL cases (1%-17%) than for the DLBCL cases (1.4%-58%). Oncogene expression also differed in the 2 lymphoma subtypes, with p53 expression occurring more frequently in the BLL group and Bcl-2 protein expression being much more common in the DLBCL cases.
Expression of CAMs and the CD44 homing receptor was strikingly different in the DLBCL and BLL groups. Loss of at least one CAM and loss of CD44 expression were found in all but one case of BLL (92%), but only 27% of the DLBCL cases lost CAMs and only 14% lost CD44 (Figure 3).
Molecular genetic studies
Genetic characteristics were evaluated in all BLL cases for which adequate tissue remained. Results of the molecular genetic studies are summarized in Table 3. Briefly, in situ hybridization for EBER1 RNA was performed on paraffin sections from the 10 BLL cases and the 25 DLBCL cases for which paraffin blocks were available. The analysis was positive in 3 BLL cases, including 1 HIV-negative case and 2 HIV-positive cases. In all the positive cases, most of the lymphoma cell nuclei showed nuclear expression of EBER1. Of the 25 DLBCL cases tested, none were positive for EBER1.
FISH studies for identification of the t(8;14) translocation were done successfully in 5 of 9 BLL and 3 of 3 DLBCL paraffin-block samples (more extensive FISH studies on DLBCL samples were outside the scope of this study). The indeterminate FISH studies were considered uninterpretable because of a lack of hybridization signal caused by fixation-related DNA degradation. Four of the 5 BLL patients with interpretable results (80%) had t(8;14), with 66% to 80% of the nuclei positive. None of the DLBCL patients had t(8;14).
PCR analysis for the MBR of the t(14;18) translocation was done successfully on DNA extracted from frozen blocks of tissue from 18 of the 55 patients with DLBCL, paraffin blocks from 9 BLL patients, and paraffin blocks from an additional 25 of the 55 DLBCL patients. None of the tested BLL patients had t(14;18). In contrast, PCR analysis for the MBR of t(14;18) yielded positive results in 6 of the 43 DLBCL patients studied (14%).
Clinical outcome
Of the 68 patients with lymphoma in this study, 43 (10 with BLL and 33 with DLBCL) were treated with a second- or third- generation, doxorubicin-containing regimen as described previously.8Only these 43 patients with homogeneously staged disease (bulky stage II, III, and IV) and homogeneous treatment were included in the survival analysis (Figure 6). The results indicated a reduction of more than 50% in median survival time for BLL patients compared with DLBCL patients (1.2 years versus 2.5 years), whereas 5-year survival rates were remarkably similar (40% of BLL patients versus 42% of DLBCL patients). Although the survival curves converged and were comparable after 5 years, there was a marked difference in initial 1-year survival, with less than 50% for the BLL patients and approximately 85% for the DLBCL patients.
Discussion
Distinguishing BLL from DLBCL is difficult, even for expert hematopathologists. However, in a series of classic cases of BLL in which all SWOG reviewers confirmed the histologic diagnosis, we found several phenotypic, genotypic, and clinical differences between the lymphoma categories. Both BLL cases and DLBCL cases had a mature B-cell phenotype, but the BLL cases had a higher level of expression of CD10 antigen (common-acute-lymphoblastic leukemia). Differences in oncogene expression and proliferative rate also distinguished BLL from DLBCL. The BLL cases had a low frequency of Bcl-2 oncoprotein expression and a high frequency of p53 tumor suppressor gene expression. The increased p53 expression is similar to that reported in BL20 21 and, with the low Bcl-2 protein expression, contrasts with the findings in DLBCL.
The BLL cases showed a consistently higher proliferative rate, with a mean of 88% Ki-67–positive cells, compared with a mean of 53% Ki-67–positive cells in the DLBCL cases. Our percentages of Ki-67–positive cells were slightly lower than the proliferative rates determined in some studies of BL and BLL. This can be explained by slight differences in the methods used for counting Ki-67 cells. The percentages of Ki-67–positive cells in our study were determined by counting all cells on frozen sections, including background cells of various types, a method that produced slightly lower proliferative rates than an analysis that included malignant cells only. The high Ki-67 proliferative rate in our BLL cases is similar to that in previous reports3,9 and is also similar to that reported for pediatric BL.5 A high level of Ki-67 expression was previously shown to be associated with a high risk of early death,9 a finding confirmed in this study.
This study was predominantly a comparison of phenotypic features in BLL and DLBCL, but limited molecular analyses were also performed. It was outside the scope of this study to conduct complete genetic analyses of the DLBCL cases, and no BL subgroup samples were available in the SWOG repository for comparisons. We found that the genetic features in our group of BLL patients were very different from those reported for DLBCL and were similar to previously reported findings in BL. EBV was detected in 14% of HIV-negative patients with BLL in this study, which was comparable to the reported frequency in nonendemic BL.22-24 The t(14;18)(q32;q21), JH/Bcl-2 translocation, commonly found in 20% to 40% of patients with DLBCL,25-30 was observed in 14% of our DLBCL cases but was not found in any case of BLL. The t(8;14) translocation, which involves the c-Myc locus on chromosome 8q24, was identified in 80% (4 of 5) of our successfully tested BLL cases. This occurrence of the t(8;14) translocation without a coexisting t(14;18) translocation was previously observed in some cases of small noncleaved cell, non-Burkitt lymphomas.31,32 The frequency of t(8;14) in our BLL cases was similar to that reported in BL.32,33 The t(8;14) translocation is infrequently observed in DLBCL.30 The dysregulation of the c-Myc locus that occurs as a consequence of the t(8;14) translocation, frequently in tandem with other oncogene abnormalities, is typically associated with a loss of growth control and a very high proliferative rate.
Another distinctive phenotypic feature of the BLLs is the common occurrence of a loss of CAM expression, particularly CD11a/LFA-1α, CD18/LFA-1β, CD58/LFA-3, and CD54/ICAM. The BLLs have a much higher incidence of CAM abnormalities than the DLBCLs, with frequent loss of LFA and ICAM antigens. These particular CAMs were previously found to have a high rate of loss of expression in BL34-40; we here found CAM loss also to be a common feature of the BLLs. As previously observed,41 a loss of CAMs results in abnormalities in T- and B-cell interactions and diminishes immune surveillance. This is manifested by the extremely low level of tumor infiltration by cytotoxic T-cells we observed in our BLL cases (low CD8+ T-TIL numbers in 80% of BLL cases in contrast to 24% of DLBCL cases).
Although our patients with BLL were slightly younger and tended to have a better performance status than the patients with DLBCL, we found poor initial survival among BLL patients with advanced-stage disease. We identified a clinically distinct subset of patients with high-grade B-cell lymphomas who had a median survival time of 1.2 years, whereas patients with advanced-stage DLBCL had a median survival time of 2.5 years. Among the patients with BLL, there was a high percentage of deaths in the first year (> 50% versus 15% of DLBCL patients), partly reflecting the high proliferative rate of the BLLs.9 Like previous studies, we found comparable 5-year survival rates.8,42-44 In the most recent NHLCP analysis of BLL cases with disease stage and patient age comparable to those in our study, a poorer survival for patients with BLL was also observed.44
In retrospect, it is clear that the WF category of diffuse, small noncleaved-cell, non-Burkitt lymphoma (J) represented a heterogeneous group of disorders, including several lymphoma subtypes that were not recognized at all or not well characterized at the time the WF was developed. In the current study, almost half of the 75 lymphoma cases originally classified as WF category J by expert reviewers in the 1980s and early 1990s were found to lack the characteristic histologic features of de novo BLL as described in the REAL classification. These cases were reclassified several years after their original review as a different subtype of non-Hodgkin lymphoma and were excluded from this study. The reclassified cases fell into several distinct groups. The largest group (17 cases) was reclassified as DLBCL. Eight patients had a low-grade B-cell lymphoma, predominantly follicular or marginal-zone subtypes, undergoing transformation to BLL. Eight cases of mantle cell lymphoma, with or without blastic transformation, comprised the third category of reclassified cases, and 3 other cases were considered to be unclassifiable after rereview.
The lack of reproducibility we found in the histologic diagnosis of BLL parallels the results of the NHLCP, in which BLL was one of the REAL classification categories with poor agreement (53%) among expert hematopathologist reviewers.7 44 The level of agreement on the diagnosis of BLL in our study (52%) was virtually identical to that in the NHLCP study. Some insights can be gained from the histologic examination of our classic cases of BLL, which were accepted as BLL by all reviewers. It is possible that a critical analysis of histologic features that takes advantage of our current knowledge of other entities, such as mantle cell lymphoma, can identify some cases of BLL by their morphologic characteristics alone. The histologic features in these cases closely resembled those in BL, with slightly greater variability in nuclear size, more nuclear irregularity, and greater nucleolar prominence in the BLL cases. Our confirmed series of BLL cases represents a far more homogeneous collection of lymphomas than did our original series of WF category J cases.
Although making a diagnosis of BLL on the basis of morphologic review alone is challenging in many cases, our findings indicate that the BLLs have phenotypic and molecular genetic features that may be used to distinguish them from DLBCLs. Our results suggest that the BLLs are high-grade, high-initial-risk lymphomas characterized by poor initial survival compared with the DLBCLs and by the presence of oncogenic and phenotypic abnormalities similar or identical to those found in BL. Our findings here are in agreement with previous reports suggesting that initial poor survival among patients with B-cell lymphomas is highly predicted by the presence of multiple aberrant phenotypic features, including a loss of growth control, a very high proliferative rate, and loss of immune surveillance.9,41,45,46 Our results support separation of BLL from DLBCL. The similarities between our BLL cases and previously reported BL series suggest that inclusion of BLL as a variant of BL, as proposed in preliminary drafts of the World Health Organization's new classification of neoplastic diseases of the hematopoietic tissues,47 is more biologically and clinically appropriate than absorbing the BLLs into the DLBCLs. Additional studies are under way to determine whether the rare cases of DLBCL with an immunophenotype similar to that of BL and the BLLs have a similar poor clinical outcome.
We appreciate the technical assistance of Y. Frutiger, C. Rangel, and V. Bedell.
Supported by National Cancer Institute grant CA 32101, SWOG Lymphoma Biology and Cytogenetics Programs, under the auspices of the SWOG Lymphoma Repository.
The publication costs of this article were defrayed in part by page charge payment. Therefore, and solely to indicate this fact, this article is hereby marked “advertisement” in accordance with 18 U.S.C. section 1734.
References
Author notes
Rita M. Braziel, Department of Pathology, L471, Oregon Health Sciences University, 3181 SW Sam Jackson Park Road, Portland, OR 97201; e-mail: braziel@ohsu.edu.